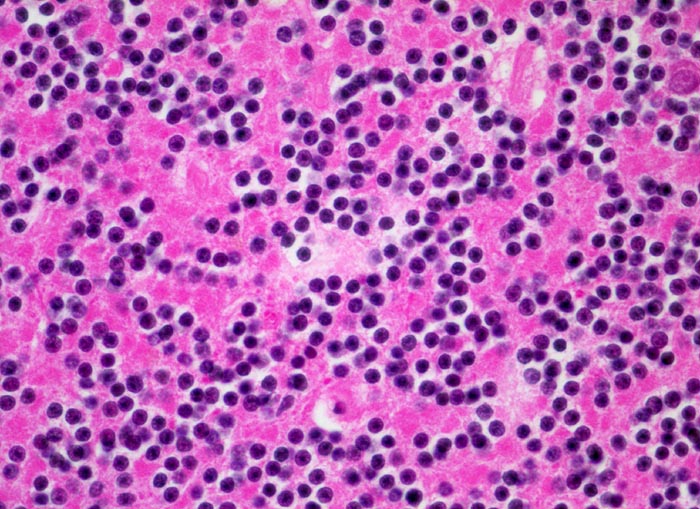

PathoPic – image database / PathoPic ID 5217 - Kleinhirn: Körnerzellschicht
de
Diagnose
Kleinhirn: Körnerzellschicht
Diagnose Gruppe
Normalbefund
Topographie
Kleinhirn
Topographie Gruppe
Nervensystem
Beschreibung
Zellreiche Körnerschicht der Kleinhirnrinde
Bilder Typ
Histologie
Vergrösserung
40
Geschlecht
weiblich
Datum
Ersteintrag: 23.07.2002